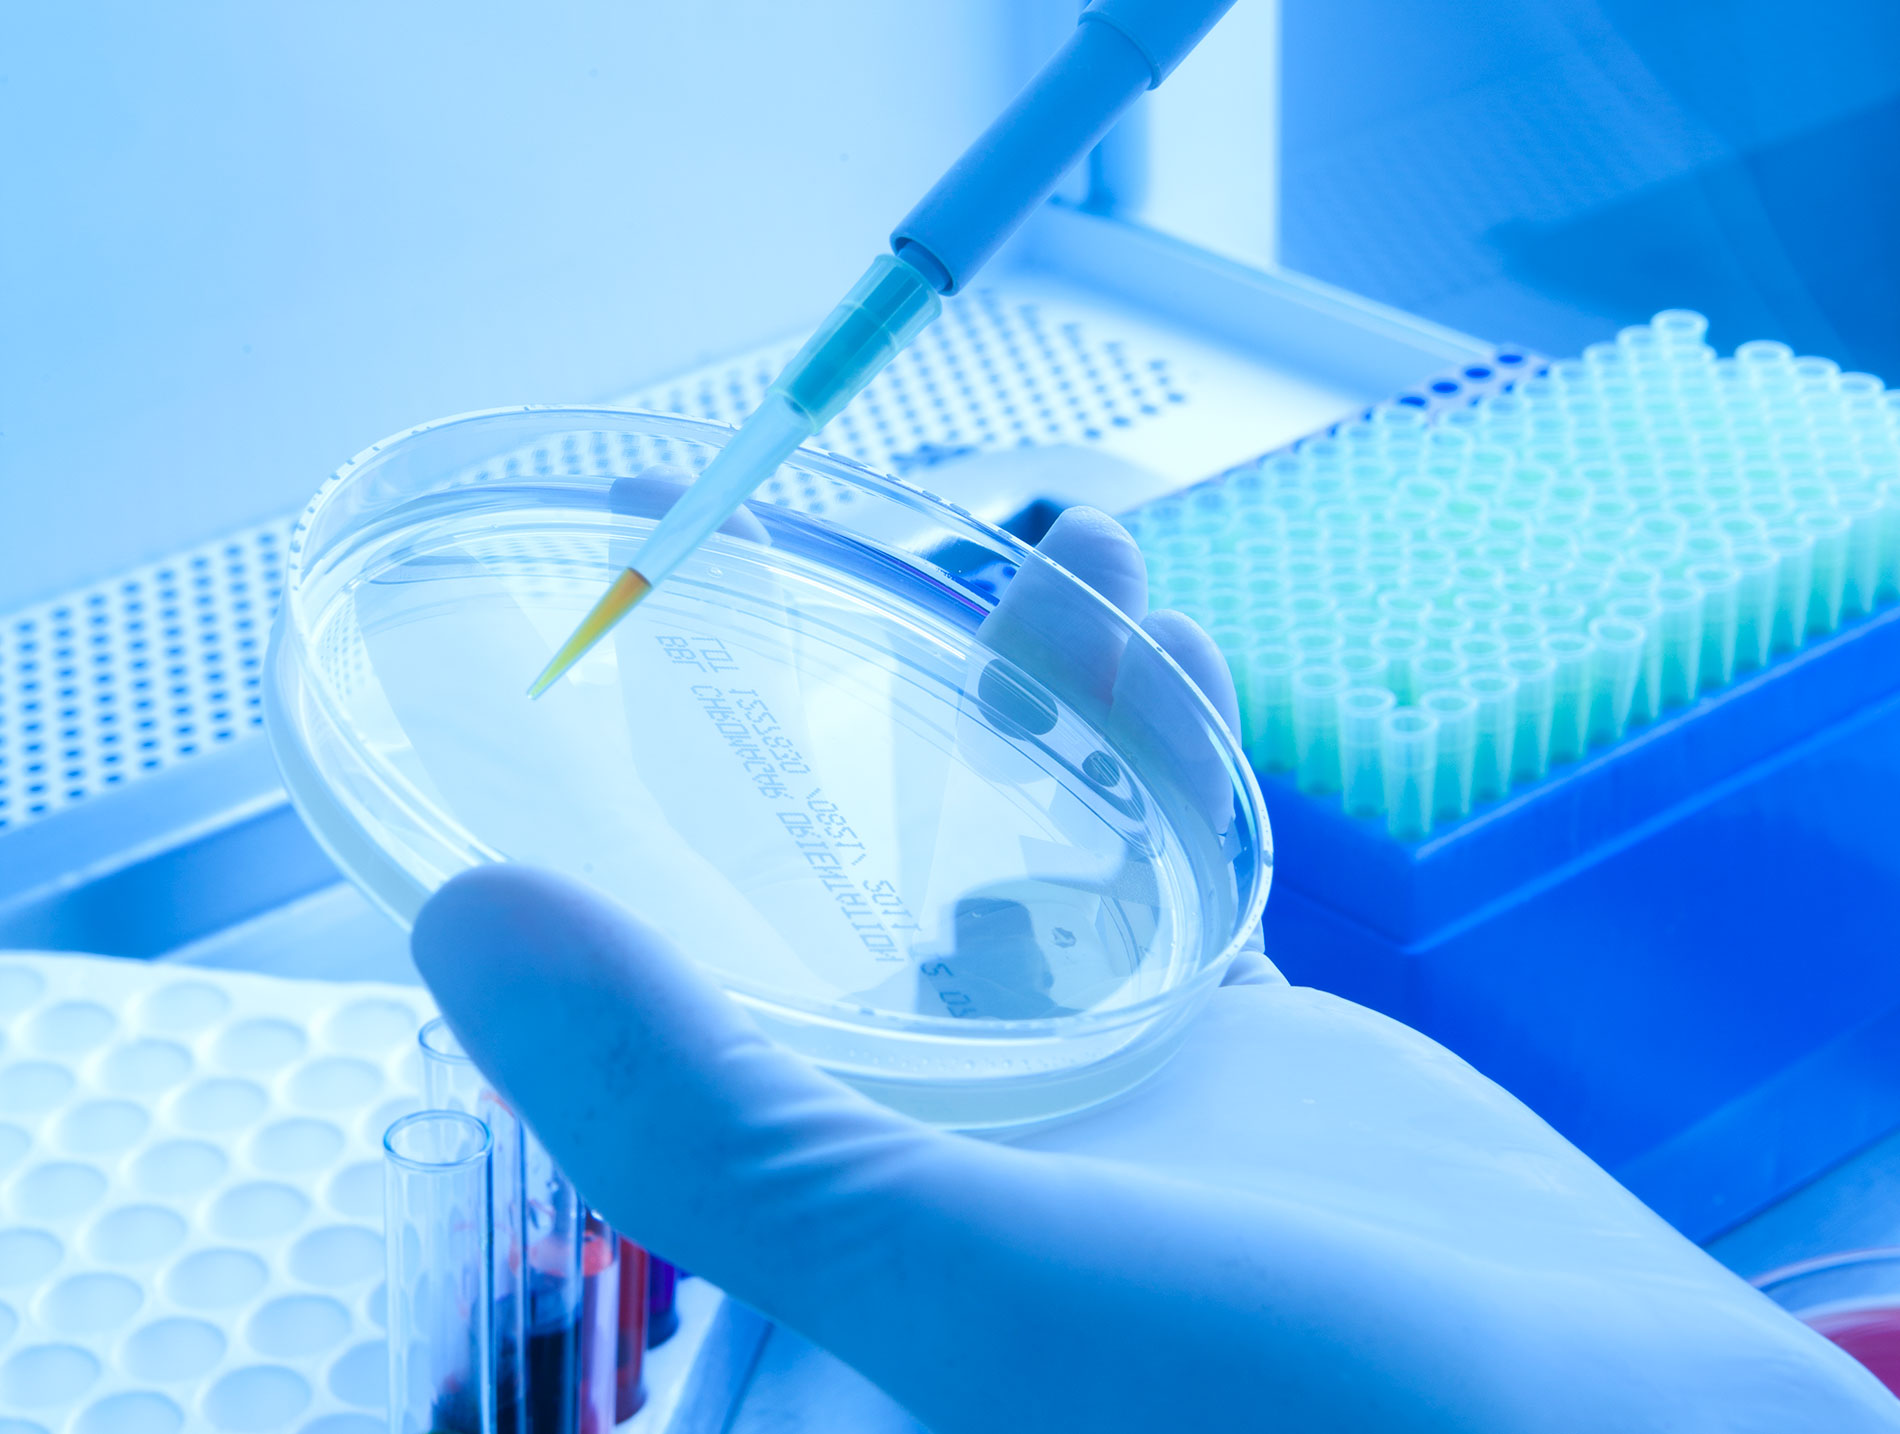

Somos una organización que contribuye efectivamente a la salud de la comunidad en general, mediante la prestación de servicios especializados en laboratorio clínico, patología, citología, medicina laboral y participamos en estudios clínicos de Centros de Investigación nacionales e internacionales. Estamos comprometidos con la satisfacción de nuestros clientes, colaboradores y demás grupos de interés, brindando una atención oportuna, segura y con calidad humana. Disponemos de personal calificado, tecnología de última generación y altos estándares de calidad que aseguran la confiabilidad en los resultados.